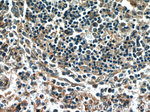
C15orf53 Antibody in Immunohistochemistry (Paraffin) (IHC (P))

Search
Proteintech
C15orf53 Polyclonal Antibody
{{$productOrderCtrl.translations['antibody.pdp.commerceCard.promotion.promotions']}}
{{$productOrderCtrl.translations['antibody.pdp.commerceCard.promotion.viewpromo']}}
{{$productOrderCtrl.translations['antibody.pdp.commerceCard.promotion.promocode']}}: {{promo.promoCode}} {{promo.promoTitle}} {{promo.promoDescription}}. {{$productOrderCtrl.translations['antibody.pdp.commerceCard.promotion.learnmore']}}
产品信息
24553-1-AP
种属反应
宿主/亚型
分类
类型
抗原
偶联物
形式
浓度
规格
纯化类型
保存液
内含物
保存条件
运输条件
产品详细信息
In our detection this antibody always detects a ~30 kDa band.
Immunogen sequence: MELQGAQED LGISLSSPRR NHETRPGSKA KGRSSICLQA SVWMAGGKLR LRASEHLTQG HQQELRDWNL GEDASLLFSK SPFGAGKLIQ APAHVFRQCW VQGNAWISCI TKFDSKRSPE VASSPSYLTV PRRSPLPVFL RPSDRCVCGG CYLGKSTRRR ACQSLLSDPL GVTFPTQTRP (1-179 aa encoded by BC119016)
靶标信息
The function of this protein remains unknown.
仅用于科研。不用于诊断过程。未经明确授权不得转售。